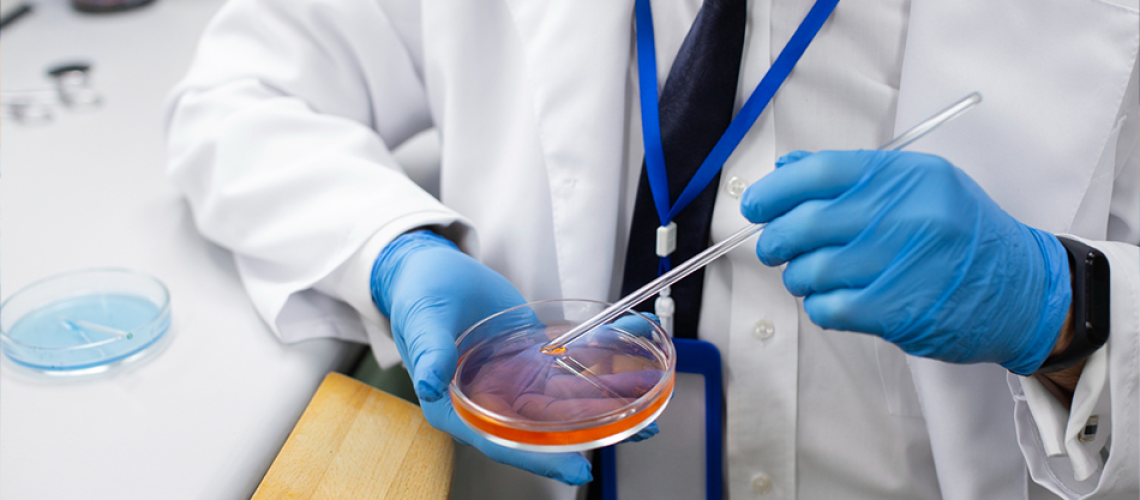
6984res_457439525-56a3c2df5f9b58b7d0d39dc1-8-2

Dr Rakesh S. Ramesh , Chandrakala M. Naidu , Apoorva D. Mavatkar , Snijesh V. P. , Vishakha Ramamurthy , Vidya M. Somashekaraiah , Anupama C. E. , Kiruthiga Raghunathan , Anuradha Panigrahi , Manjula Das , Sujan K. Dhar and Jyothi S. Prabhu
Home » Estimation of ALU repetitive element in plasma as a cost – effective liquid biopsy tool for disease prognosis in breast cancer- Cancers (ISSN 2072-6694) on 23 January 2023
Dr Rakesh S. Ramesh , Chandrakala M. Naidu , Apoorva D. Mavatkar , Snijesh V. P. , Vishakha Ramamurthy , Vidya M. Somashekaraiah , Anupama C. E. , Kiruthiga Raghunathan , Anuradha Panigrahi , Manjula Das , Sujan K. Dhar and Jyothi S. Prabhu